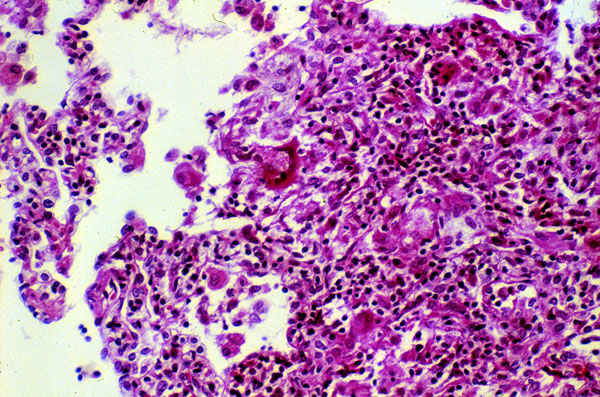

Hypersensitivity pneumonia
Click picture to enlarge. Close window to return
Hypersensitivity pneumonia is an immunologic reaction to inhaled antigens, that histologically is characterized by a chronic interstitial pneumonitis (with a predominance of lymphocytes), and interstitial non-necrotizing granulomas. This is a high power slide of a markedly thickened alveolar wall with numerous lymphocytes and occasional histiocytes and a rare multinucleated giant cell attempting to form a poorly defined interstitial granuloma.